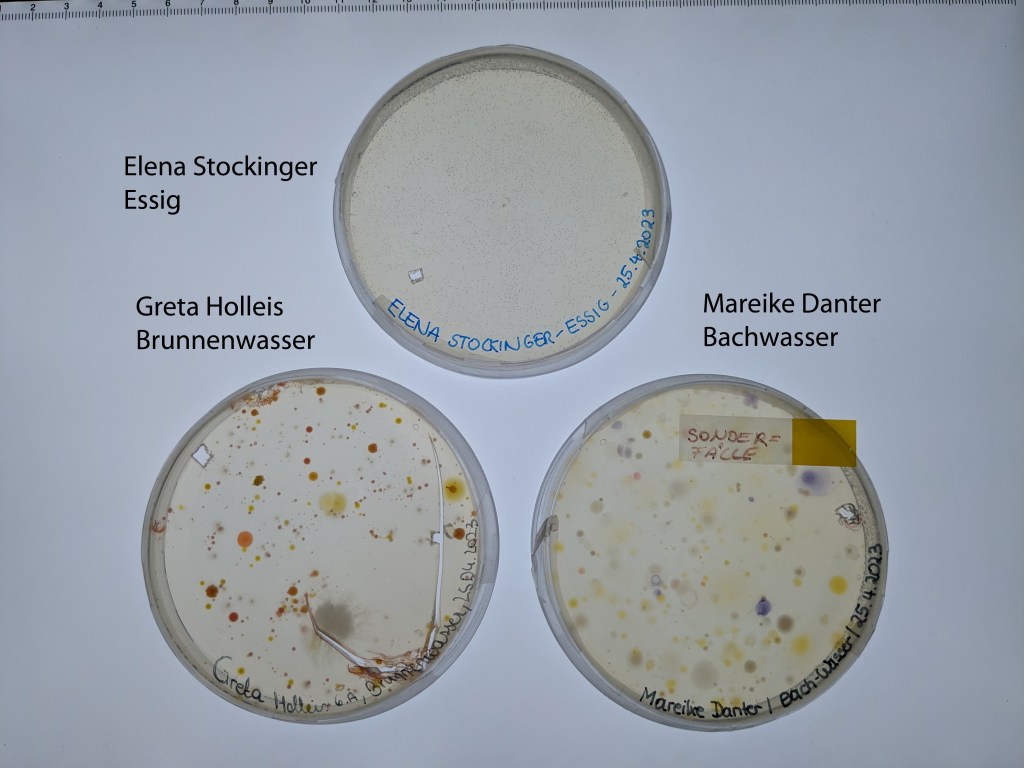
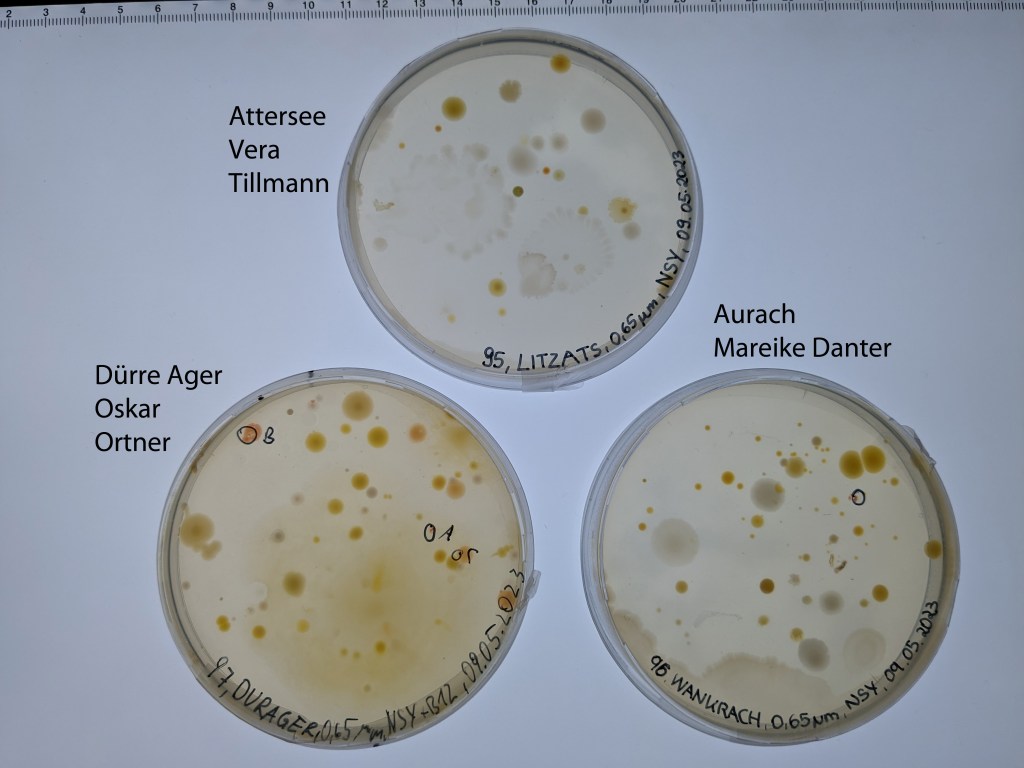
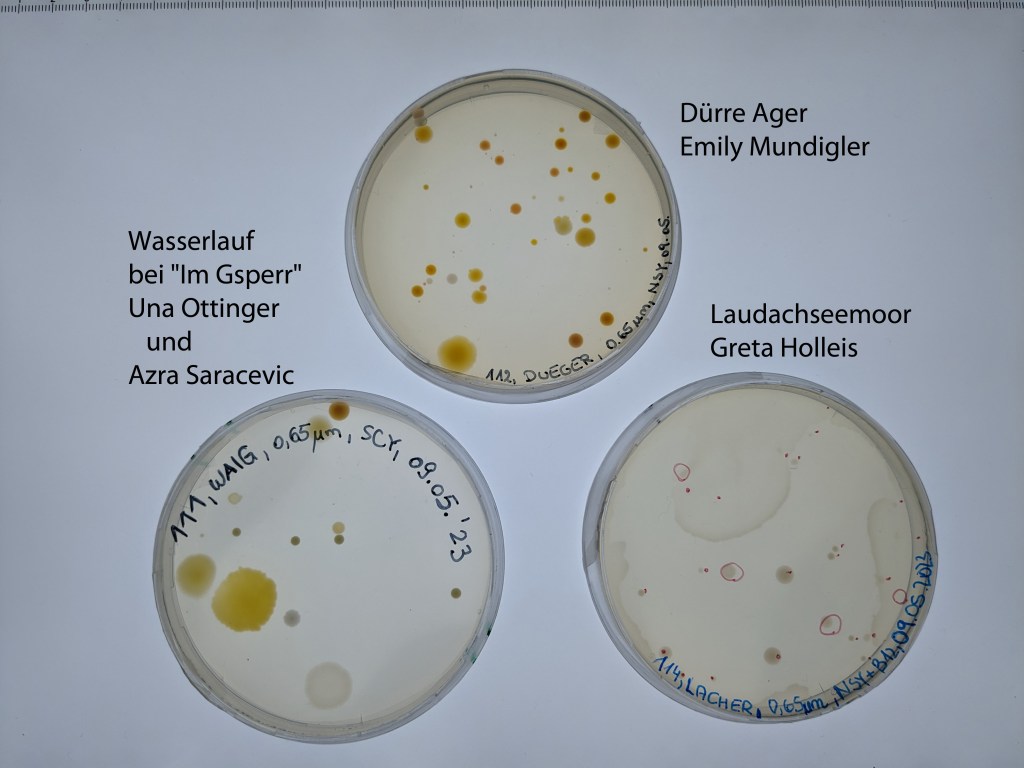
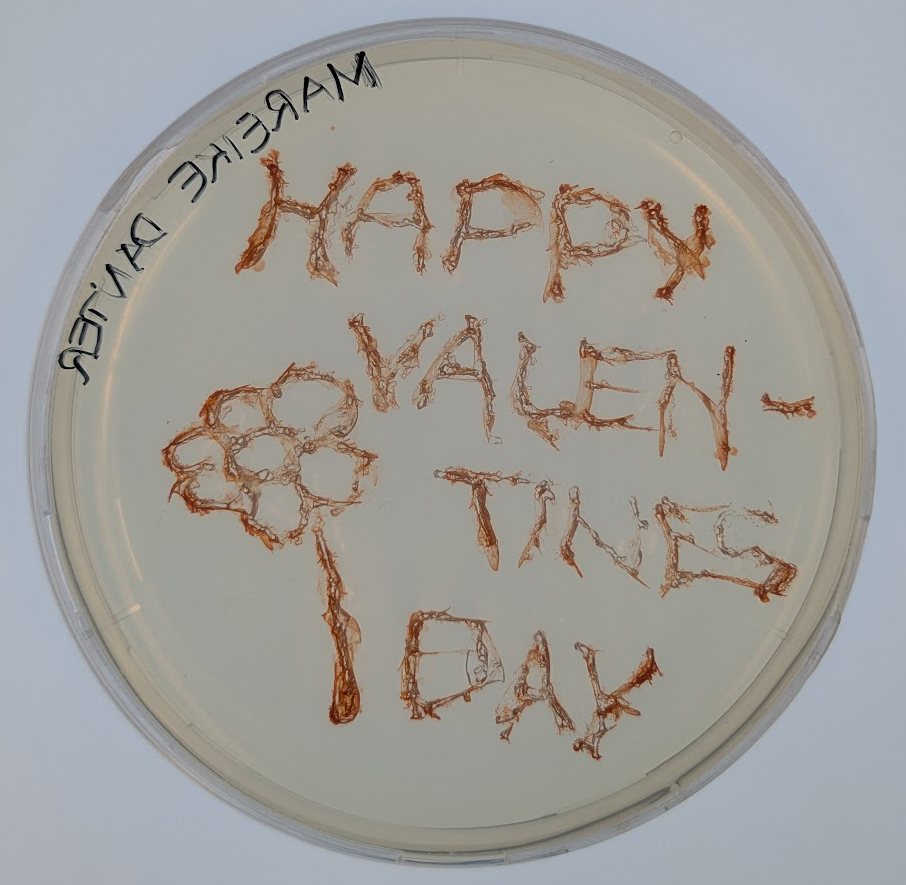
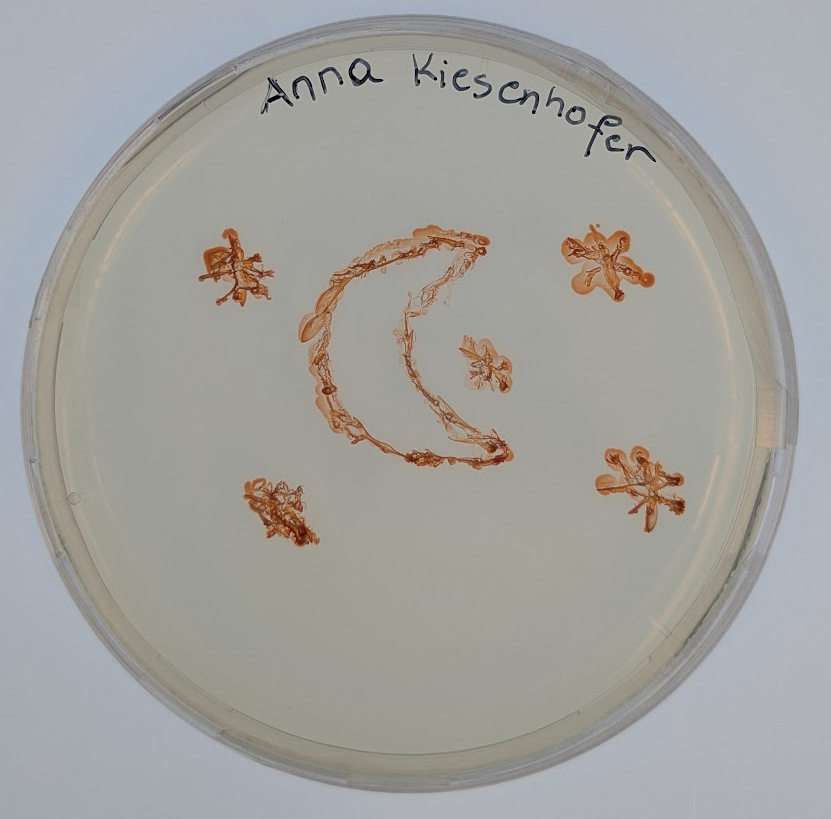

6A (2022/2023) mit Eveline Schürz

1. Workshop
Am 24.4.2023 waren wir (Alexandra, Johanna, Stefan) zum ersten Mal bei der Klasse 6A und ihrer Lehrerin Eveline Schürz im BG Vöcklabruck zu Gast. Die Anreise war wiedermal etwas schwierig… zum ganzen Beitrag

2. Workshop

Am 10.5.2023 waren wir (Alexandra, Johanna und Stefan) zum zweiten Mal am BG Vöcklabruck zu Gast. Zuerst gab es einen Vortrag zu unserem Thema, den Bakterien und insbesondere der Artenvielfalt dort….zum ganzen Beitrag
3. Die Wasserproben der Schüler/innen
Jede Schülerin und jeder Schüler hatte eine Wasserprobe von einem Gewässer seiner Wahl mitgebracht, diese filtriert und auf Agarplatten mit unterschiedlicher Zusammensetzung ausgestrichen. Die Platten von Greta und Mareike vom ersten Workshop hatten schon vielversprechende Kolonien, da hat Johanna wie auch von der ‚Essigplatte‘ von Elena gleich Kolonien aus dem Agar ausgestochen (auf dem ersten Foto zu sehen). Wir haben von den Agarplatten vom zweiten Workshop jeweils ein Exemplar fotographiert. Manche brauchen noch etwas Zeit, aber auf einigen haben wir schon typische ‚Aquirufa-rote‘ Kolonien entdeckt 🙂 . Beim Laudachseemoor von Greta haben wir noch nichts rotes entdeckt (das sind nur Johannas Markierungen 😉 ), dafür aber andere für uns spannende Bakterien.
4. Der Weg zu den Aquirufa Kulturen
Von den Agarplatten haben wir uns die Kolonien rausgesucht, die das typische ‚Aquirufa-Rot‘ zeigen. Diese haben wir vorsichtig mit einem (sterilisierten 😉 ) Zahnstocher in flüssiges Medium gegeben (Platte links). Dort konnten sich die Bakterienzellen weiter vermehren. Wenn die Kultur das typische Rot aufwies, haben wir davon wieder ein wenig auf eine Agarplatte pipettiert und mit einer Impföse (das sind die langen Stäbe im Bild) verteilt.

Im Bild sieht man die Flüssigkulturen. Sie stehen auf einem Schüttler in kleinen Erlenmeyerkolben und werden leicht geschaukelt, damit die Bakterien genug Luft bzw. Sauerstoff zur Verfügung haben. Inzwischen haben wir eine ganze Menge davon und müssen aufpassen, dass wir noch den Überblick behalten 😉 .

Und so sieht unser Fach im Kasten mit den Kulturen auf Agarplatten aus. Es sind ebenfalls eine ganze Menge. Zur Aufreinigung wird jeweils eine Kolonie aus einer Agarplatte ausgestochen und in flüssiges Medium gegeben. Das wiederholt man vier Mal, um eine Reinkultur, also eine Bakterienkultur, die nur Zellen von einem einzigen Bakterienstamm enthält, zu bekommen.

Um zu erfahren, ob die erhaltenen Bakterienstämme wirklich zur Gattung Aquirufa gehören, wird ein kleiner Abschnitt der DNA sequenziert. Dazu machen wir erst eine PCR und schicken das erhaltene Material zu Eurofins nach Deutschland.

Inzwischen haben wir aus sieben Gewässern von den Wasserproben des BG Vöcklabruck Bakterienkulturen, die zur Gattung Aquirufa gehören. Bei einigen können wir schon eine Zuordung zu bekannten Arten machen, erstaunlicherweise beherbergen manche Gewässer sogar mehrere Arten. Um sicher zu wissen, ob auch neue Arten darunter sind, werden wir von einigen Bakterienstämmen das gesamte Genom sequenzieren lassen.

Und das sind die Gewässer, aus denen wir bis jetzt Aquirufa-Kulturen erhalten haben: Vöckla (VOEKFU-92, Isabella Kammerer), Griebach/Neudorfer Bach in Rutzenmoos (GRIRUBA-93, Christina Kroismayr), Aurach (WANKRACH-96, Mareike Danter), Dürre Ager (DURAGER-97, Oskar Ortner), Teich in Friesam (FRTEICH-102, Xaver Golmayer), Vöckla (VOEKLAB-107, Matthias Reiterer), Dürre Ager (DUEGER-112, Emily Mundigler).
5. Besondere Kulturen
Aus den von Greta Holleis von einer Wasserprobe aus dem Laudachseemoor angelegten Agarplatten haben wir eine Bakterienkultur gewinnen können, die zur Gattung Polynucleobacter gehört. Das ist eine Bakteriengruppe mit der sich unsere Arbeitsgruppe sehr intensiv beschäftigt. Sie kommt insbesondere in sauren Gewässern vor. Vielen Dank an Greta!

Ausserdem waren da noch die interessanten Bakterien von einer Agarplatte auf die Essig ausgestrichen worden war. Elena Stockinger hatte sie angelegt und wir haben die Bakterien 🧫 identifiziert. Sie gehören zur Gattung Komagataeibacter. Ein komplizierter Name, aber sie spielen tatsächlich bei der Essigproduktion eine Rolle. Manche können Cellulose produzieren. Auf den Philippinen werden sie zur Produktion eines Desserts🍧 Nato de Coco verwendet. Dazu lässt man sie in Kokosmilch 🥥wachsen. Bei uns im Labor wachsen sie auch in Kugeln, wie man auf dem Foto sieht, da müsste nur noch etwas Zucker und Farbstoff dazu 😋 Es gibt also durchaus neben unseren Aquirufa Gewässerbakterien noch andere spannende Bakterien 😉.
6. Erste Publikation erschienen
Unsere erste wissenschaftliche Publikation im Projekt ist erschienen und hier verfügbar.
Sie enthält die Beschreibung einer neuen Bakterienart aus dem Leopoldskroner Weiher. Sie ist eine wirkliche Gemeinschaftsarbeit. Unsere Kooperationspartner von der DSMZ Braunschweig und den GUE Austria sowie Schülerinnen und Schüler vom BORG Nonntal, dem BG Vöcklabruck und dem BRG Schloss Wagrain haben mitgewirkt. Alle sind in der Danksagung namentlich erwähnt. Ganz ❤️ lichen Dank 😊.

7. Workshop zur Datenauswertung
Am 27.2.2024 waren Alexandra und Stefan wieder bei der Klasse 7a im BG Vöcklabruck zu Gast. Gemeinsam wurden die Daten zu den Bakterienstämmen aus den Wasserproben der Schüler/innen analysiert. Aus fast der Hälfte konnten wir Kulturen von unserer Bakteriengattung Aquirufa gewinnen. Sehr interesant ist zum Beispiel FRTEICH-102D4 aus einem Teich bei Friesham. Er gehört zwar zur Gattung Aquirufa antheringensis ist aber relativ weit entfernt verwandt mit den anderen Stämmen von Aquirufa antheringensis verwandt. Er könnte sich auf dem Weg befinden, eine neue Art zu bilden.
8. Besuch im Forschungsinstitut in Mondsee
Zum Abschluss hat uns die Klasse mit ihrer Lehrerin Stefanie Steinparzer in Mondsee besucht. Eveline Schürz ist inzwischen Mutter geworden und in Karenz. Zuerst wurden Neuigkeiten ausgetauscht. Wir haben berichtet wie die Mitarbeit der Schüler/innen einen Beitrag zu unserer Forschung geleistet hat. Die Klasse hat von ihrer Artnamensuche mit ihrer Latein-Lehrerin Birgit Grübl erzählt. Die geplanten Namen für unsere korsische Bakterienarten hören sich sehr spannend an 🙂. Dann wurde das Institut und unser Labor erkundet, Wasserproben am Mondsee genommen und das Plankton im Mikroskop angeschaut. Die Partybrezeln 🥨 kamen nach anfänglichen Problemen doch noch und so konnten wir den Vormittag mit einer gemeinsamen Jause abschließen. Wir danken allen recht ❤️lich fürs Mitmachen im Projekt und wünschen alles Gute für die Matura 🍀.
Herzlichen Dank auch an Sebastian fürs spontane Mithelfen!
9. Agarart
Bei ihrem Besuch bei uns hatten die Schüler/innen auf Agarplatten mit einer Flüssigkultur der Aquirufa Bakterien gemalt. Hier sind die tollen Kunstwerke:
10. Wissenschaftliche Publikation erschienen
Unsere 3. wissenschaftliche Publikation ist erschienen und hier online verfügbar. Ca. 130 Citizen Scientist haben dabei mitgewirkt. Sechs Schulklassen und weitere Citizen Scientists haben Wasserproben aus selbst gewählten Gewässern genommen…hier gehts zum Beitrag